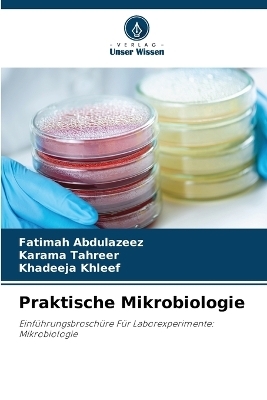
Praktische Mikrobiologie

Buch | Softcover
2025
|
Verlag Unser Wissen
ISBN: 9786208485085
CHF 39,95 (inkl. MwSt)
- Titel nicht im Sortiment